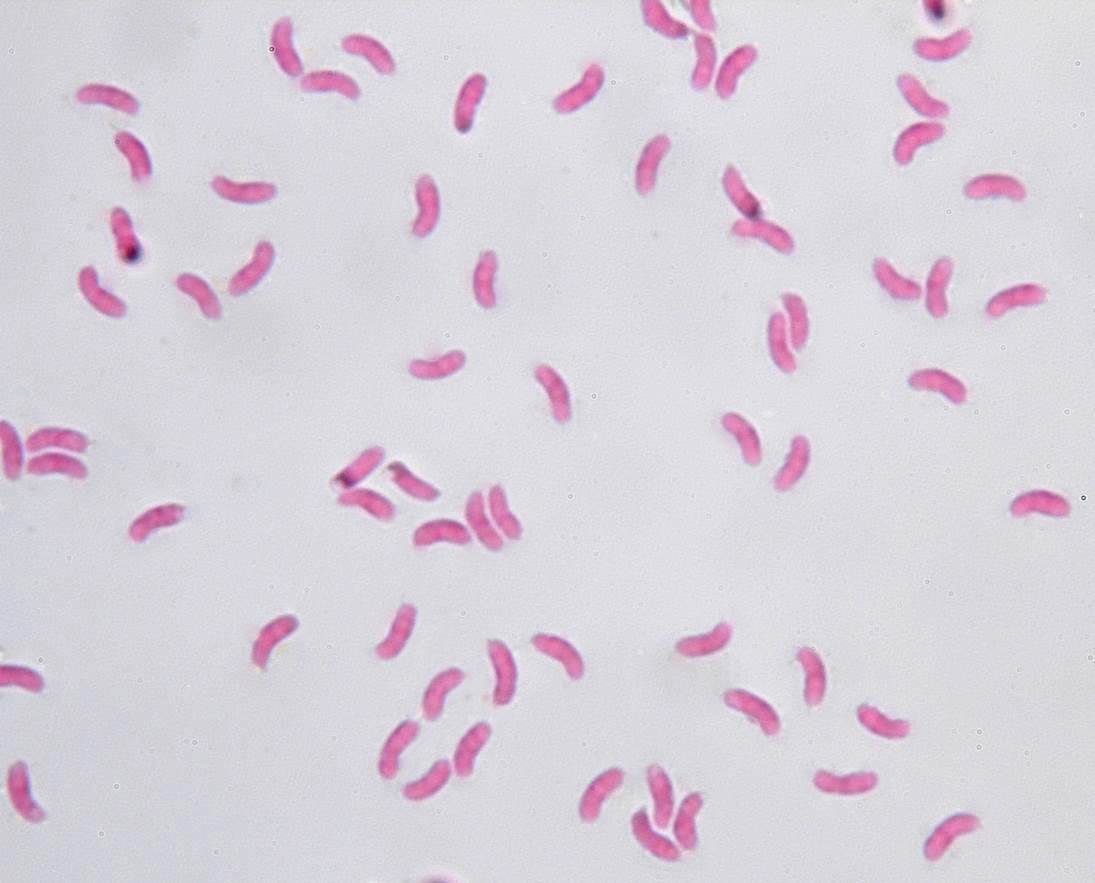

Antrodia xantha
Gelbe Braunfäuletramete, Gelblicher Resupinatporling
Das obige Foto zeigt die Gelbe Braunfäuletramete (fm. pachymeres) zwar in typischer Wuchsform, aber sehr blassem Gelb, das man eher als weißlich bezeichnen würde. Die in frischem Zustand gelbliche Farbe verblasst sukzessive mit dem Altern. Mit den bekannten Trameten hat der Pilz freilich keine Ähnlichkeit und steht auch nicht in der Gattung Trametes.
Werner Pohl hat den Pilz als nahezu unverwechselbar bezeichnet und in seinem Aphyllopower.Blogspot so beschrieben:
Dieser hübsche kleine Porling wird in der BRD überwiegend in der Form pachymeres gefunden, welche aus kleinen, dachziegelig übereinander wachsenden, hängenden Hütchen besteht. Wer die kleinen, ausgedehnt wachsenden, Fruchtkörperansammlungen, die mit Vorliebe Stümpfe von Nadelholz überziehen und etwas an die mittelalterlichen Felsengräber von Myra erinnern, einmal gefunden hat, wird sie leicht wieder erkennen. Rein resupinate, gelbliche Fruchtkörper, welche auch als Schadpilze in Gebäuden auftreten können, sind viel seltener. Die länglich-dreieckigen Hütchen der f. pachymeres haben im Jugendzustand kleine und oft blass- bis zitringelbe Poren mit Maßen von 4 -6 per mm.”
Der an senkrechten Totholzfächen wachsende Porling kann je nach Substratangebot Überzüge von einigen Dezimetern Größe bilden. Die Hütchen können vereinzelt oder in kleineren Gruppen auf dem Subikulum verteilt oder großflächig miteinander verwachsen sein. Die Poren (6 - 8 pro mm) sind rundlich bis eckig oder auch zerschlitzt. In frischem Zustand riecht der Pilz nach Zitrone und schmeckt bitter. Mit zunehmendem Altern verschwindet der Geruch und der Pilz wird bröckelig. Im Holz verursacht er eine Braunfäule.
Verwechselt werden könnte er mit der wesentlich häufigeren und an gleichen Substraten wachsenden Reihigen Tramete Antrodia serialis, die sich leicht vom Substrat ablösen lässt und auch mikroskopisch durch größere Sporen (6,5 - 9 x 3 - 4 µm) unterscheidet (A. xantha: 4 - 5 x 1 - 1,5 µm, allantoid, glatt, dünnwandig, hyalin). Für mich stellte die Frage, ob es sich bei der leichten Ablösbarkeit um ein Alleinstellungsmerkmal oder zumindest um ein praktisch anwendbares Unterscheidungsmerkmal handelt, ein zunächst unlösbares Problem dar. In der gesamten mir zugänglichen Literatur und auch bei Internet-Recherchen fand ich zu Antrodia xantha nicht die gewünschte Auskunft. Schließlich gelang Bernd Miggel die Aufklärung: A. Berniccia schreibt zu Antrodia xantha “aderenti sul substrato” (am Substrat haftend) und auch Ryvarden & Melo formulieren es deutlich: A. xantha: “adnate” (angewachsen), A. serialis: “easily peeled off in one piece” (leicht in einem Stück abziehbar).